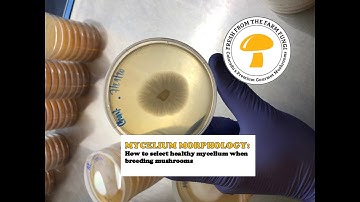
MYCELIUM MORPHOLOGY: how to select healthy mycelium when breeding mushrooms
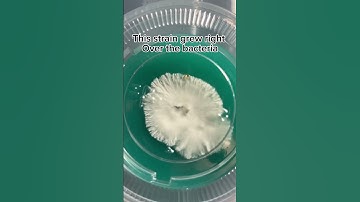
Mushroom Mycelium Vs Bacteria #mushroom #information #bacteria #contamination #mycelium

⬇ DOWNLOAD NOW
Kalau muncul iklan pop-up, tutup lalu klik tombol kembali
Download lagu Identifying mushroom mycelium vs bacteria and the importance of observing plates secara gratis hanya untuk keperluan promosi. Dukung artis favorit kamu dengan membeli musik original di iTunes atau platform resmi lainnya.
 Mushroom Contamination - Bacillus (Wetspot) and Trichoderma (Green Mold)
Mushroom Contamination - Bacillus (Wetspot) and Trichoderma (Green Mold)
MYCELIUM MORPHOLOGY: how to select healthy mycelium when breeding mushrooms
MYCELIUM MORPHOLOGY: how to select healthy mycelium when breeding mushrooms
 Identifying bacteria on petri dishes (mushroom cultivation from spores) 36 hour update
Identifying bacteria on petri dishes (mushroom cultivation from spores) 36 hour update
Mushroom Mycelium Vs Bacteria #mushroom #information #bacteria #contamination #mycelium
Mushroom Mycelium Vs Bacteria #mushroom #information #bacteria #contamination #mycelium
 Agar plate streaking
Agar plate streaking
 This time-lapse was taken over 16 day from colonization to fruiting with a GoPro. 📷🍄
This time-lapse was taken over 16 day from colonization to fruiting with a GoPro. 📷🍄
 Checking If Agar Plates Are Contaminated #contamination #agar #mushroom #mycelium
Checking If Agar Plates Are Contaminated #contamination #agar #mushroom #mycelium
 When Your Mushroom Monotub is Almost Ready for Fruiting Conditions - Colonization with Pins #shorts
When Your Mushroom Monotub is Almost Ready for Fruiting Conditions - Colonization with Pins #shorts